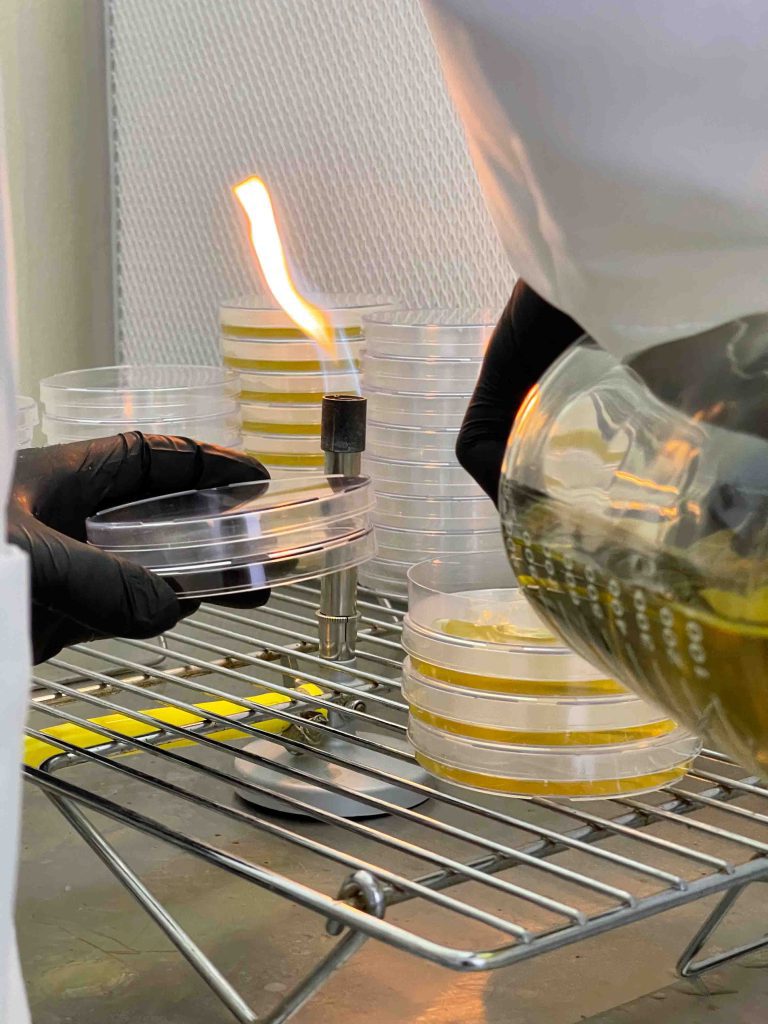
Fungi Pharma

Fungi Pharma
Galería de Fungi Pharma:
Innovación y Calidad Visual
Visita nuestra galería para ver fotos de nuestros procesos de cultivo y las últimas novedades de la empresa. Te invitamos a conocer cómo trabajamos para ofrecerte productos de alta calidad.